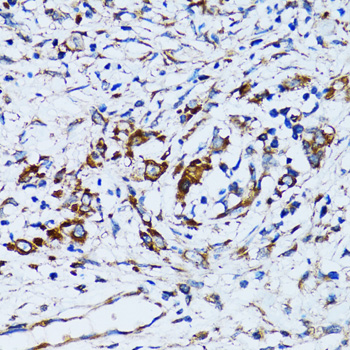
Immunohistochemistry - RARS Polyclonal Antibody

-
Product Name
RARS Polyclonal Antibody
- Documents
-
Description
Polyclonal antibody to RARS
-
Tested applications
WB, IHC, IF
-
Species reactivity
Human, Mouse, Rat
-
Alternative names
RARS antibody; ArgRS antibody; DALRD1 antibody; HLD9 antibody; arginyl-tRNA synthetase antibody
-
Isotype
Rabbit IgG
-
Preparation
Antigen: Recombinant fusion protein containing a sequence corresponding to amino acids 1-300 of human RARS (NP_002878.2).
-
Clonality
Polyclonal
-
Formulation
PBS with 0.02% sodium azide, 50% glycerol, pH7.3.
-
Storage instructions
Store at -20℃. Avoid freeze / thaw cycles.
-
Applications
WB 1:500 - 1:2000
IHC 1:50 - 1:200
IF 1:10 - 1:100 -
Validations

Western blot - RARS Polyclonal Antibody
Western blot analysis of extracts of various cell lines, using RARS antibody at 1:1000 dilution._Secondary antibody: HRP Goat Anti-Rabbit IgG (H+L) at 1:10000 dilution._Lysates/proteins: 25ug per lane._Blocking buffer: 3% nonfat dry milk in TBST._Detection: ECL Enhanced Kit ._Exposure time: 30s.

Immunohistochemistry - RARS Polyclonal Antibody
Immunohistochemistry of paraffin-embedded rat brain using RARS antibody at dilution of 1:100 (40x lens).

Immunohistochemistry - RARS Polyclonal Antibody
Immunohistochemistry of paraffin-embedded human lung cancer using RARS antibody at dilution of 1:100 (40x lens).
Immunohistochemistry - RARS Polyclonal Antibody
Immunohistochemistry of paraffin-embedded human uterine cancer using RARS antibody at dilution of 1:100 (40x lens).

Immunohistochemistry - RARS Polyclonal Antibody
Immunohistochemistry of paraffin-embedded mouse spinal cord using RARS antibody at dilution of 1:100 (40x lens).

Immunohistochemistry - RARS Polyclonal Antibody
Immunohistochemistry of paraffin-embedded mouse brain using RARS antibody at dilution of 1:100 (40x lens).

Immunofluorescence - RARS Polyclonal Antibody
Immunofluorescence analysis of MCF-7 cells using RARS antibody . Blue: DAPI for nuclear staining.
-
Background
Forms part of a macromolecular complex that catalyzes the attachment of specific amino acids to cognate tRNAs during protein synthesis. Modulates the secretion of AIMP1 and may be involved in generation of the inflammatory cytokine EMAP2 from AIMP1.
Related Products / Services
Please note: All products are "FOR RESEARCH USE ONLY AND ARE NOT INTENDED FOR DIAGNOSTIC OR THERAPEUTIC USE"
